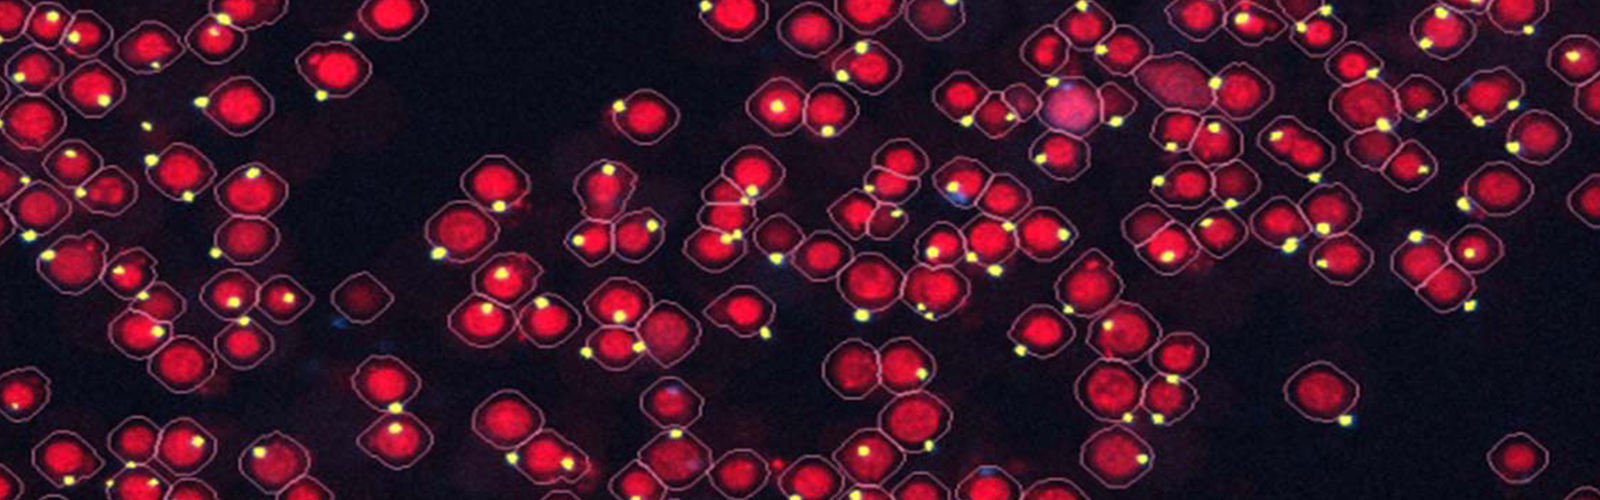
inflammasome

Our lab is a part of the Division of Innate Immunity in the Department of Medicine and the Program in Innate Immunity, an interdisciplinary and interdepartmental group of investigators, who are focused on discovering the underlying mechanisms that drive immune defenses and inflammation in both health and disease.
Research focus: understanding molecular mechanisms controlling inflammatory response
- Sensing and signaling in innate immunity (TLRs, Inflammasomes, cGAS/STING)
- Autoinflammatory diseases (e.g., SAVI - STING associated Vasculopathy with onset in Infancy)
- Therapeutic targeting of Inflammasomes and cGAS/STING Signaling
Representative publications
- Chen Y, Lei X, Jiang Z, Fitzgerald KA. Cellular nucleic acid-binding protein is essential for type I interferon-mediated immunity to RNA virus infection. Proc Natl Acad Sci U S A. 2021 Jun 29;118(26):e2100383118.
- Shmuel-Galia L, Humphries F, Lei X, Ceglia S, Wilson R, Jiang Z, Ketelut-Carneiro N, Foley SE, Pechhold S, Houghton J, Muneeruddin K, Shaffer SA, McCormick BA, Reboldi A, Ward D, Marshak-Rothstein A, Fitzgerald KA. Dysbiosis exacerbates colitis by promoting ubiquitination and accumulation of the innate immune adaptor STING in myeloid cells. Immunity. 2021 Jun 8;54(6):1137-1153.e8.
- Motwani M, McGowan J, Antonovitch J, Gao KM, Jiang Z, Sharma S, Baltus GA, Nickerson KM, Marshak-Rothstein A, Fitzgerald KA. cGAS-STING Pathway Does Not Promote Autoimmunity in Murine Models of SLE. Front Immunol. 2021 Mar 29;12:605930.